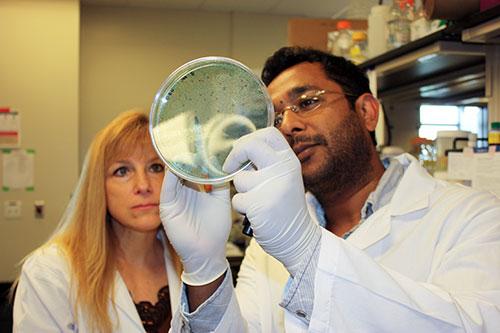

What Starts Here Changes the World
The College of Pharmacy is internationally recognized for groundbreaking research that is among the highest quality in the nation.
Funding to support research is in excess of $20 million and comes from competitive grant proposals from the National Institutes of Health, pharmaceutical companies, and private foundations.
Learn more with our brochure describing faculty research initiatives.
College Divisions
Chemical Biology & Medicinal Chemistry
The Division of Chemical Biology and Medicinal Chemistry works at the nexus of Chemistry and Biology, generating chemical and biochemical tools to study mechanisms of cell signaling, biosynthetic pathways, enzyme evolution, DNA repair and other therapeutic targets for drug design.
Health Outcomes
The mission of the Health Outcomes Division is to be a leader in addressing population and individual patient health through innovative, high-quality research and education, and to serve our community by responding to critical health care issues that impact patients’ daily lives.
Molecular Pharmaceutics & Drug Delivery
Molecular Pharmaceutics and Drug Delivery is comprised of those disciplines that are involved with dosage forms in pharmaceutical practice. Sub-disciplines within the division include formulation science, biopharmaceutics, and pharmacokinetics.
Pharmacology & Toxicology
Research in the Division of Pharmacology and Toxicology encompasses studies investigating basic and translational mechanisms of drug action, the neuropharmacology of addiction, environmental factors that impact health and lead to disease, DNA repair and genetic instability, and cancer biology, treatment, and prevention.
Pharmacotherapy & Translational Sciences
The mission of the Division of Pharmacotherapy & Translational Sciences is to train and educate student pharmacists, graduate students, and postdoctoral fellows to provide specialty pharmacotherapeutic services, including acute and primary care, and to conduct translational, transdisciplinary, and other types of innovative research.
Pharmacy Practice
The focus of the Division of Pharmacy Practice is excellence in innovative Pharm.D. teaching through didactic, interprofessional, experiential, and service-based learning experiences. Students learn by serving patients and the community through clinical practice and outstanding patient care.